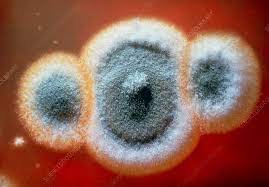
Penicillium mold showing antibiotic effect

Back
BackAntimicrobial Drugs: Mechanisms, Spectrum, Resistance, and Clinical Considerations
Study Guide - Smart Notes

Antimicrobial Drugs
Introduction to Antimicrobial Agents
Antimicrobial drugs are substances used to treat infections by targeting pathogenic microorganisms. They are a cornerstone of modern medicine, enabling the treatment of bacterial, fungal, protozoal, and viral diseases.
Drugs: Substances that produce physiological effects in the body.
Chemotherapeutic Agents: Drugs used to combat diseases.
Antimicrobial Agents: Drugs specifically designed to treat infections.


Historical Development of Antimicrobial Agents
The discovery and development of antimicrobial agents revolutionized the treatment of infectious diseases.
Paul Ehrlich: Proposed the concept of "magic bullets"—chemicals that specifically target microbes without harming the host. Developed arsenic-based drugs.
Alexander Fleming: Discovered penicillin from the mold Penicillium, the first true antibiotic.
Gerhard Domagk: Discovered sulfanilamide, the first widely used synthetic antimicrobial agent.
Selman Waksman: Coined the term "antibiotics" and identified antimicrobial substances produced by microorganisms.
Classification of Antimicrobial Drugs
Types of Antimicrobial Drugs
Antimicrobial drugs are classified based on their origin and chemical modification.
Antibiotics: Naturally produced by microorganisms (e.g., bacteria, fungi).
Semisynthetic Drugs: Naturally occurring antibiotics chemically modified to improve effectiveness, stability, or spectrum.
Synthetic Drugs: Entirely created through chemical synthesis in the laboratory.
Spectrum of Action
The spectrum of action refers to the range of pathogens affected by a drug.
Narrow-spectrum: Effective against a limited group of organisms.
Broad-spectrum: Effective against a wide variety of organisms.
Clinical caution: Broad-spectrum drugs may disrupt normal microbiota, leading to superinfections.

Mechanisms of Action of Antimicrobial Drugs
Overview of Drug Targets
Antimicrobial drugs act by interfering with essential microbial processes.
Cell wall synthesis
Protein synthesis
Cytoplasmic membrane integrity
Metabolic pathways
Nucleic acid synthesis

Common Antibacterial Drugs by Mode of Action
Antibacterial drugs are classified based on their mechanism of action and target within the bacterial cell.
Mode of Action | Target | Drug Class |
|---|---|---|
Inhibit cell wall biosynthesis | Penicillin-binding proteins | β-lactams, penicillins, cephalosporins, monobactams, carbapenems |
Inhibit biosynthesis of proteins | 30S/50S ribosomal subunit | Aminoglycosides, tetracyclines, macrolides, lincosamides, oxazolidinones |
Disrupt membranes | Lipopetides/polymyxins, inner and outer membranes | Polymyxin B, colistin, daptomycin |
Inhibit nucleic acid synthesis | RNA, DNA | Rifamycins, fluoroquinolones |
Antimetabolites | Folic acid synthesis enzyme | Sulfonamides, trimethoprim |
Mycobacterial ATP synthase inhibitor | Mycobacterial ATP synthase | Bedaquiline |

Inhibition of Cell Wall Biosynthesis
Drugs targeting cell wall synthesis are highly effective against bacteria due to the unique structure of bacterial cell walls.
β-lactam antibiotics: Block cross-linking of NAM subunits in peptidoglycan, weakening the cell wall and causing lysis.
Semisynthetic derivatives: Modified to improve stability, absorption, and resistance to enzymatic degradation (e.g., amoxicillin, methicillin).
Only effective against actively growing cells: These drugs do not affect existing peptidoglycan.



Inhibition of Fungal Cell Wall Synthesis
Fungal cell walls contain unique polysaccharides, making them good drug targets.
Echinocandins: Block glucan synthesis, weakening the fungal cell wall.
Antifungal drugs: Target several cell structures, including chitin and ergosterol.

Inhibition of Protein Synthesis
Protein synthesis inhibitors exploit differences between prokaryotic (70S) and eukaryotic (80S) ribosomes.
Aminoglycosides: Bind 30S subunit, causing faulty proteins.
Macrolides, lincosamides, chloramphenicol: Bind 50S subunit, preventing peptide bond formation.
Tetracyclines: Block tRNA binding to 30S subunit.
Oxazolidinones: Prevent formation of 70S initiation complex.
Mupirocin: Selectively inhibits isoleucyl-tRNA synthetase, blocking isoleucine attachment to tRNA (effective against Gram-positive bacteria).



Disruption of Cytoplasmic Membranes
Some drugs compromise membrane integrity, leading to cell death.
Nystatin & Amphotericin B: Bind ergosterol in fungal membranes, creating pores.
Azoles & Allylamines: Inhibit ergosterol synthesis.
Polymyxin: Disrupts Gram-negative bacterial membranes; toxic to human kidneys.


Inhibition of Metabolic Pathways
Drugs target metabolic pathways unique to pathogens.
Atovaquone: Disrupts electron transport in protozoa and fungi.
Heavy metals: Inactivate enzymes.
Tubulin & glucose inhibitors: Block polymerization or uptake in protozoa and worms.
Antiviral agents: Block viral activation, attachment, or uncoating.
Metabolic antagonists: Compete with natural substrates (e.g., sulfonamides inhibit folic acid synthesis).



Inhibition of Nucleic Acid Synthesis
Drugs that block DNA replication or RNA transcription are often toxic to both prokaryotic and eukaryotic cells.
Quinolones & Fluoroquinolones: Target DNA gyrase in bacteria.
Nucleotide/Nucleoside analogs: Distort DNA/RNA structure, blocking replication and transcription (e.g., acyclovir for viral infections).
RNA polymerase inhibitors: Block RNA synthesis.
Reverse transcriptase inhibitors: Target HIV replication; safe for humans.




Clinical Considerations in Prescribing Antimicrobial Drugs
Effectiveness and Laboratory Testing
Diffusion susceptibility test (Kirby-Bauer): Measures zone of inhibition around drug discs.
Minimum Inhibitory Concentration (MIC): Lowest concentration preventing visible growth.
Minimum Bactericidal Concentration (MBC): Lowest concentration killing the microbe.




Routes of Administration
Topical: Applied to skin or mucous membranes.
Oral: Taken by mouth; convenient.
Intramuscular (IM): Injected into muscle; slower absorption.
Intravenous (IV): Directly into bloodstream; rapid effect.
Safety and Side Effects
Toxicity: May harm kidneys, liver, or nervous system.
Therapeutic index: Ratio of tolerated dose to effective dose; higher values are safer.
Allergies: Rare but potentially life-threatening.
Disruption of normal microbiota: Can lead to secondary infections and overgrowth of opportunistic pathogens.
Antimicrobial Drug Resistance
Development and Spread of Resistance
Natural resistance: Some pathogens are inherently resistant.
Acquired resistance: Occurs via chromosomal mutations or acquisition of resistance genes (R plasmids) through horizontal gene transfer (conjugation, transformation, transduction).
Mechanisms of Microbial Resistance
Enzymatic degradation/modification: Bacteria produce enzymes (e.g., beta-lactamase) that destroy or alter drugs.
Target modification: Alteration of drug targets (e.g., MRSA modifies penicillin-binding proteins).
Active efflux pumps: Transport drugs out of the cell.
Reduced permeability: Altered membrane prevents drug entry.
Metabolic bypass: Alternative pathways circumvent drug action.
Multiple Resistance and Cross Resistance
Multiple resistance: Resistance to several drugs, often via R plasmid exchange.
Cross resistance: Resistance to structurally similar drugs.
Retarding Resistance
Use drugs only when necessary.
Complete prescribed courses.
Use combinations of drugs (synergism).
Limit use of broad-spectrum agents.
Summary Table: Common Antibacterial Drugs by Mode of Action
Mode of Action | Target | Drug Class |
|---|---|---|
Inhibit cell wall biosynthesis | Penicillin-binding proteins | β-lactams, penicillins, cephalosporins, monobactams, carbapenems |
Inhibit biosynthesis of proteins | 30S/50S ribosomal subunit | Aminoglycosides, tetracyclines, macrolides, lincosamides, oxazolidinones |
Disrupt membranes | Lipopetides/polymyxins, inner and outer membranes | Polymyxin B, colistin, daptomycin |
Inhibit nucleic acid synthesis | RNA, DNA | Rifamycins, fluoroquinolones |
Antimetabolites | Folic acid synthesis enzyme | Sulfonamides, trimethoprim |
Mycobacterial ATP synthase inhibitor | Mycobacterial ATP synthase | Bedaquiline |
Key Points for Exam Preparation
Understand the difference between antibiotics, semisynthetic, and synthetic drugs.
Know the concept of selective toxicity and its importance.
Be able to classify mechanisms of action and give examples.
Differentiate between narrow and broad-spectrum antimicrobials.
Identify factors and mechanisms leading to antimicrobial resistance.
Recognize clinical considerations in prescribing antimicrobial drugs.
